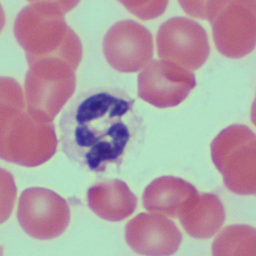

We designtools for researchers
Problem-solving is complex. Tools make complexity manageable.
We design computer vision tools tailored to your use case, so you can think deeper, not dig harder.
This demo is optimized for desktop devices. Please view on a PC or tablet for the full experience.
Graphical User Interface (GUI) for intuitive and efficient code access. Full screen.
C:\Users\researcher\Documents\RedBloodCells\Samples\2024-11-10-Demo
| Name | Size | Format | Modified |
|---|---|---|---|
| No images loaded | |||
We combat complexity
Complex sample identification


Pixel-level precision


Overlapping object detection

discuss how computer vision can accelerate your workflow.
clarify requirements, goals, and expectations.
no background information needed.
typical turnaround within one week. All training data will be deleted afterwards
ready-to-use tools with documentation and support.
We typically respond within 24 hours
Schedule a consultation
Prefer texting? Send us a message